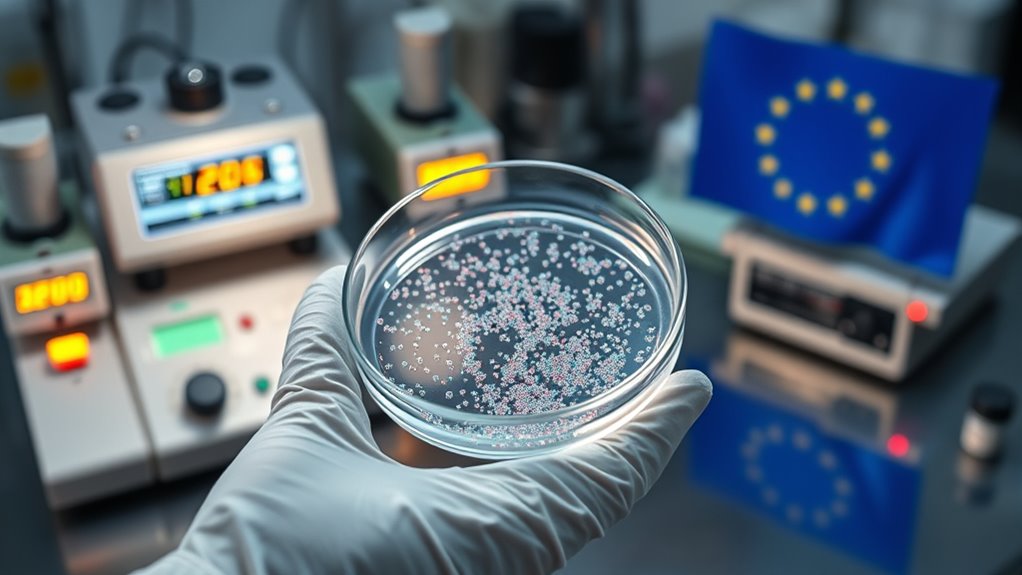
eu bans nanomaterials in cosmetics

Regulation struggles to keep pace with nanotech because existing laws often don’t address the unique risks of nanoscale materials. Agencies like the US EPA and European regulators are developing special rules for nanomaterials, but gaps and inconsistencies remain worldwide. Cross-border coordination is challenging, and innovation often outpaces regulation. If you want to understand how governments are trying to adapt, there’s more to explore about global efforts and future strategies.
Key Takeaways
- Existing regulations like TSCA and EU laws aim to address nanomaterials but often lag behind rapid technological advancements.
- International efforts seek to harmonize safety standards, yet legal and procedural differences hinder comprehensive regulation.
- Regulatory frameworks face challenges in keeping pace with nanotech innovation due to limited testing, data gaps, and enforcement issues.
- Governments are investing in infrastructure and policy coordination to better monitor and manage nanotechnology risks.
- Rapid sector growth demands adaptive laws that can evolve swiftly to ensure safety without stifling innovation.

AURSINC NanoVNA Testboard Kit, Test Demo Set Tool Compatible with DIP Quickly Assemble a Simple RF Circuit and Evaluate Performance on NanoVNA H H4 Antenna Analyzer
The Testboard kit allows NanoVNA users to assemble a useful component jig to quickly build a simple RF…
As an affiliate, we earn on qualifying purchases.
As an affiliate, we earn on qualifying purchases.
Navigating the US EPA’s Approach to Nanoscale Materials

To effectively navigate the US EPA’s approach to nanoscale materials, you need to understand how the agency regulates these substances under the Toxic Substances Control Act (TSCA). The EPA uses consent orders and Significant New Use Rules (SNURs) to oversee nanomaterials, requiring premanufacture notifications that detail chemical identity, production volume, manufacturing methods, uses, exposure risks, releases, and health data. The agency enforces controls like limiting specific uses, mandating personal protective equipment, and restricting environmental releases. Testing requirements are also imposed to assess safety. Effective preparation involves understanding the specific regulatory pathways for nanomaterials to ensure compliance and safety. However, exemptions exist for tightly controlled exposures, allowing some flexibility. Additionally, the EPA’s information gathering rule applies to both new and existing nanomaterials, ensuring exhaustive oversight and data collection to manage potential risks effectively. Attention to detail is vital for identifying and understanding potential hazards associated with nanomaterials in regulatory processes. The development of clear regulatory frameworks is essential for keeping pace with rapid advancements in nanotechnology and ensuring public safety. Recognizing the evolving regulatory landscape helps stakeholders adapt their practices accordingly, especially as the technology continues to advance at a rapid rate.

Advanced Materials and Conversion Technologies for Personal Protective Equipment Used in the COVID-19 Pandemic (Materials Horizons: From Nature to Nanomaterials)
As an affiliate, we earn on qualifying purchases.
As an affiliate, we earn on qualifying purchases.
EU’s Strict Regulations on Cosmetic Nanomaterials
The European Union has implemented strict regulations on the use of nanomaterials in cosmetics, reflecting its commitment to consumer safety. Under Commission Regulation (EU) 2024/858, specific nanomaterials are prohibited or restricted, including colloidal gold and platinum nanoparticles. These rules aim to minimize potential health risks associated with nano-sized ingredients by controlling their use and disclosure. The regulation came into force on April 4, 2024, with a marketing ban starting February 1, 2025, and a total ban effective November 1, 2025. As a consumer or manufacturer, you need to stay informed about these bans to guarantee compliance. The EU’s approach emphasizes precaution, transparency, and stringent oversight to protect public health while regulating cosmetic products containing nanomaterials. Forsale 100 Additionally, these regulations reflect the importance of regulating nanotech to keep pace with rapidly evolving technologies. Ensuring proper nanomaterial safety measures is crucial for maintaining consumer trust and fostering innovation within the industry. Moreover, the EU’s focus on transparency and oversight highlights the need for ongoing research into potential long-term health effects of nanomaterials, considering the rapid development of nanotechnologies that outpace existing regulations.
cosmetic nanomaterials regulation compliance
As an affiliate, we earn on qualifying purchases.
As an affiliate, we earn on qualifying purchases.
Cross-Border Coordination Between Canada and the US

You need to understand how Canada and the US are working to align their nanotechnology regulations through initiatives like the RCC Nanotechnology Initiative and shared policy principles. Despite these efforts, significant policy gaps remain, especially in managing cross-border trade and safety standards. These harmonization challenges require ongoing dialogue and coordination to guarantee effective, consistent regulation across borders. Effective regulation is essential for ensuring safety and fostering innovation in the rapidly advancing field of nanotech. Additionally, establishing clear regulatory standards can help prevent potential legal and safety issues that may arise from discrepancies between national policies.
Regulatory Alignment Efforts
Cross-border coordination between Canada and the US has become a key focus in nanotechnology regulation, aiming to reduce regulatory gaps and facilitate trade. The Canada-U.S. RCC Nanotechnology Initiative, launched in 2011, developed the Nanotechnology Work Plan to align policies and improve transparency. This effort ensures new substances are regulated under CEPA and TSCA, fostering consistent oversight. To illustrate, the table below highlights their shared goals, areas of cooperation, and remaining challenges:
| Goals | Areas of Cooperation | Challenges |
|---|---|---|
| Regulatory alignment | Data sharing | Differing legal frameworks |
| Transparency improvements | Joint risk assessments | Industry compliance |
| Trade facilitation | Policy harmonization | Cross-border enforcement |
These efforts promote a unified approach, helping both countries manage nanotech risks effectively. Regulatory frameworks play a crucial role in supporting these collaborations by providing a clear structure for oversight and compliance. Additionally, cross-border coordination enhances the effectiveness of regulatory measures by enabling resource sharing and joint decision-making.
Cross-Border Policy Gaps
How effectively are Canada and the US closing their policy gaps in nanotechnology regulation? While they launched the Canada-U.S. RCC Nanotechnology Initiative in 2011 and created a Nanotechnology Work Plan, significant gaps remain. The US primarily regulates nanomaterials through TSCA, focusing on premanufacture notifications and testing, whereas Canada emphasizes transparency under CEPA. Despite efforts to align policies, differences persist in handling nanomaterials in food, cosmetics, and chemicals. These regulatory disparities can hinder trade and pose risks to health and environment. Although bilateral initiatives promote coordination, full harmonization remains elusive. Without unified standards, companies face compliance challenges, and regulators struggle to ensure consistent safety measures across borders. Bridging these gaps requires more concerted efforts and political will to develop integrated, clear regulations. Additionally, a comprehensive understanding of nanomaterial safety and its implications is crucial for effective regulation and cross-border cooperation.
Harmonization Challenges
Despite the efforts of the Canada-U.S. RCC Nanotechnology Initiative, harmonization remains a challenge. The US regulates nanomaterials mainly through TSCA, emphasizing risk management and industry notifications, while Canada’s approach under CEPA focuses on thorough oversight and transparency. These differing frameworks create gaps that complicate cross-border trade and regulation. The US’s flexible exemptions contrast with Canada’s stricter controls, risking inconsistent safety standards. Both countries aim for aligned policies, yet legal and procedural differences hinder full coordination. International efforts, like NANORIGO and H2020, seek to bridge these gaps, but political will and stakeholder engagement are critical. Achieving harmonization requires ongoing dialogue, shared standards, and mutual recognition to ensure safe, seamless innovation across borders.
nanoparticle hazard assessment tools
As an affiliate, we earn on qualifying purchases.
As an affiliate, we earn on qualifying purchases.
The Challenge of Harmonizing Global Nanotech Policies

Harmonizing global nanotech policies presents a significant challenge because different jurisdictions often adopt contrasting approaches to regulation, safety standards, and permissible uses. You face the complexity of aligning regulations across borders, which can hinder international trade and innovation. To address this, efforts include:
- Developing international frameworks like NANORIGO and H2020 projects that promote risk governance and cooperation.
- Coordinating policies between countries, such as the Canada-U.S. RCC Nanotechnology Initiative, to ensure regulatory consistency.
- Addressing conflicting laws, like the US’s focus on chemical regulation and the EU’s restrictions on nanoscale materials in cosmetics, which can create trade barriers.
- Establishing standardized classification systems for nanomaterials to facilitate clearer communication and regulation across regions.
Furthermore, creating harmonized safety standards can help mitigate risks and promote confidence in nanotech products worldwide. Without harmonization, differences in regulation may lead to unsafe products slipping through the cracks or unnecessary trade disruptions, ultimately impacting global health, safety, and economic growth.
The Role of the U.S. National Nanotechnology Initiative

You need to understand how the U.S. National Nanotechnology Initiative (NNI) plays a key role in coordinating policies and building infrastructure to support responsible nanotech development. Funding challenges and infrastructure needs are central to ensuring safe, innovative progress across federal agencies. Addressing these issues is essential for maintaining U.S. leadership and fostering international cooperation in nanotechnology regulation. Additionally, understanding Soul Sanctuaries can offer insights into how holistic approaches can complement scientific regulation efforts.
Policy Coordination Challenges
The U.S. faces significant policy coordination challenges with nanotech regulation. You need to navigate overlapping agencies, conflicting standards, and international differences. The U.S. National Nanotechnology Initiative (NNI) tries to unify efforts but struggles with:
- Aligning federal agencies like EPA, FDA, and CPSC on nanoscale safety standards.
- Harmonizing policies with international partners like the EU and Canada.
- Ensuring consistent regulations amid evolving technologies and scientific data.
- Promoting interagency communication to prevent duplication and gaps in regulation. Additionally, establishing clear regulatory frameworks is vital for adapting to rapid technological advancements. Building comprehensive safety standards across agencies can help address these challenges effectively. Strengthening regulatory enforcement is also crucial to ensure compliance and safety.
These issues create gaps and overlaps, making it hard to develop clear, effective policies. You must balance innovation with safety, streamline regulatory efforts, and foster international cooperation. Without better coordination, nanotech regulation risks becoming fragmented, hindering safe development and global trade. The NNI’s role is essential but needs more resources and political support. Effective regulation depends on overcoming these coordination hurdles to ensure safety without stifling innovation.
Funding and Infrastructure Development
Funding and infrastructure development are critical for advancing the U.S. nanotechnology sector, with the National Nanotechnology Initiative (NNI) playing a central role in coordinating these efforts. The NNI aims to expand facilities, improve instrumentation, and develop a skilled workforce. To support growth, Congress plans to reauthorize the NNI as the National Nanotechnology Infrastructure within two years. The 2025 Quadrennial Review emphasizes renewing infrastructure and studying resource needs for state-of-the-art facilities. You should focus on investments in fabrication, synthesis, characterization, and data analysis. These efforts ensure the sector stays innovative and competitive. The table below highlights key infrastructure priorities:
| Infrastructure Area | Focus | Goal |
|---|---|---|
| Fabrication | Equipment upgrades | Higher precision manufacturing |
| Characterization | Advanced tools | Better nanoscale analysis |
| Data Systems | Data sharing platforms | Improved research collaboration |
| Workforce Development | Training programs | Skilled nanotech professionals |
| Facilities | New research centers | Expanded research capacity |
A new sentence with infrastructure upgrades and the rest of the sentence. Additionally, ongoing investments in research facilities are essential for maintaining technological leadership in nanotech development. Continued funding initiatives are vital to keep pace with rapid technological advances and ensure the sector’s long-term growth.
State-Level Movements and Their Impact on Nanotech Regulation

State-level movements considerably influence nanotech regulation by shaping policies that can either complement or challenge federal standards. You’ll see states like California pushing to regulate nanomaterials as chemical substances, often going beyond federal rules. These efforts can accelerate safety measures or complicate compliance for industries. For example:
- California’s proposed regulation excludes de minimis exemptions, increasing scrutiny.
- Legislation like AB 1083 threatens existing CEQA exemptions for nanotech projects.
- States may implement stricter reporting or testing requirements, creating a patchwork of rules.
Your business must navigate these varying regulations, which can lead to delays or added costs. While state actions can drive innovation and safety, they can also create conflicts, making it harder to develop consistent national standards. Staying informed is essential to compliance.
Global Efforts and Future Directions in Nanomaterial Governance

Global efforts are increasingly shaping the future of nanomaterial governance as countries work to establish consistent safety standards and regulatory frameworks. You’ll notice initiatives like the US EPA’s TSCA regulations, which require detailed premanufacture notifications and testing, and the EU’s strict bans on certain nanomaterials in cosmetics, set to fully implement by 2025. Canada and the US collaborate through the RCC Nanotechnology Initiative, promoting regulatory transparency and alignment. Despite differences, there’s a push toward harmonization via international forums like NANORIGO and H2020 projects, emphasizing risk governance and data sharing. Looking ahead, expanding infrastructure and reauthorizing programs like the NNI will be pivotal. These efforts aim to create a cohesive global approach, ensuring nanotech advances safely without stifling innovation or disrupting trade.
Frequently Asked Questions
How Do Different Countries Define and Categorize Nanomaterials Legally?
You’ll find that countries define and categorize nanomaterials differently. The US EPA regulates nanoscale materials under TSCA, focusing on safety and exposure limits, while the EU bans certain nanomaterials in cosmetics, emphasizing clear classifications. Canada and the US collaborate for regulatory alignment, but conflicts remain, especially with food standards. These varying definitions impact international trade, requiring ongoing efforts for harmonization and unified approaches to nanomaterial regulation across borders.
What Are the Economic Implications of Strict Nanotech Regulations on Industry?
Strict nanotech regulations can substantially increase your industry costs due to compliance, testing, and reporting requirements. You might face delays in product development and market entry, impacting profitability. Regulations also push you to invest in specialized infrastructure and safety measures, potentially limiting innovation. While aiming to protect health and the environment, these rules may create barriers for small businesses and increase prices for consumers, affecting competitiveness and market growth.
How Effective Are International Treaties in Harmonizing Nanomaterial Safety Standards?
International treaties can be effective in harmonizing nanomaterial safety standards by fostering cooperation and setting common guidelines. They help reduce trade conflicts, improve risk assessment consistency, and promote shared research efforts. However, their success depends on countries’ willingness to adopt and enforce these standards, which can vary due to differing national regulations, priorities, and resources. Strong diplomatic engagement and ongoing dialogue are vital for these treaties to truly enhance global nanomaterial safety.
What Challenges Exist in Monitoring Nanomaterial Releases in Real-Time?
You face a maze of swirling particles, tiny yet persistent, making real-time monitoring a formidable task. As nanomaterials drift into air, water, or soil, detecting their minute presence demands advanced sensors and rapid data analysis. You must contend with diverse environments, inconsistent regulations, and the challenge of distinguishing engineered nanomaterials from natural ones—all while ensuring safety without overwhelming systems with data. This ongoing struggle highlights the complexity of keeping up with nanotech’s subtle, pervasive releases.
How Will Emerging Technologies Influence Future Nanotech Regulatory Frameworks?
Emerging technologies will push nanotech regulations to adapt quickly, as new innovations often outpace current laws. You’ll see regulators developing real-time monitoring tools, advanced safety assessments, and harmonized international standards to keep up. As tech evolves, you’ll need flexible policies that address risks without stifling innovation. Active collaboration among governments, industry, and scientists will be vital, ensuring regulations stay relevant and effective while supporting responsible nanotech development.
Conclusion
Charting nanotech regulations is like chasing a fleeting shadow—you can’t always keep up. While countries and agencies endeavor to stay ahead of tiny tech’s rapid evolution, gaps and inconsistencies remain. Your role is crucial—by staying informed and advocating for smarter policies, you can help guarantee this groundbreaking technology benefits everyone without risking safety. As tiny as they are, nanomaterials demand your attention, because the future of innovation depends on how well laws catch up.